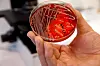
Kvart år i perioden 1990–2021 har om lag éin million menneske globalt døydd som følgje av antibiotikaresistens.

Helse
Framtidsrapport frå bakteriefronten
At antibiotika skal slutte å verke, er den store skrekken for helsevesenet verda over. Vi dykkar ned i den grundigaste prognosen som nokon gong er utført for dødsfall som følgje av motstandsdyktige bakteriar.
Kvart år i perioden 1990–2021 har om lag éin million menneske globalt døydd som følgje av antibiotikaresistens.
Foto: Cornelius Poppe / NTB
«Om vi ikkje gjer noko, vil vi stå overfor eit nesten utenkjeleg scenario der antibiotika ikkje lenger verkar og vi medisinsk er sette attende til mellomalderen.»
Orda tilhøyrer David Cameron. Han var britisk statsminister då fleire mykje siterte rapportar om antibiotikaresistens, best kjende som O’Neill-rapportane, vart lagde fram, i perioden 2014–2016.
Rapportane skisserte korleis verda ville sjå ut i 2050 dersom ein ikkje gjorde noko for å stanse antibiotikaresistente bakteriar. Dette var ei verd der 10 millionar menneske kvart år kunne døy som følgje av dei motstandsdyktige bakteriane – like mange som årleg døyr på verdsbasis som følgje av kreft i vår tid.
Dei viste fram eit verstefallsscenario der verda har mislukkast i å bremse spreiinga av dei urovekkjande organismane og betaler prisen.
Stort økonomisk tap
Den velrenommerte økonomen Jim O'Neill leia arbeidet og sa at kalkylen, som alle slike kalkylar, kunne vise seg å vere for høg. Men, sa han, dei som stod bak, trudde heller at kalkylen kunne vere for låg. For det var fleire sekundæreffektar av antibiotikaresistens dei ikkje hadde teke høgd for. Som at risikoen ved å utføre keisarsnitt, hofteoperasjonar eller tarmkirurgi ville auke.
Digital tilgang – heilt utan binding
Prøv ein månad for kr 49.
Deretter kr 199 per månad. Stopp når du vil.